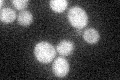
YDR379W
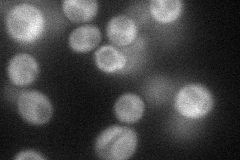
YDR379W
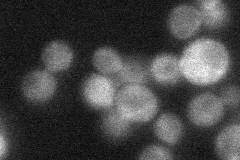
YDR379W
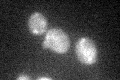
YDR379W

View description
GTPase-activating protein for the polarity-establishment protein Cdc42p; implicated in control of septin organization, pheromone response, and haploid invasive growth; regulated by Pho85p and Cdc28p
Localization:
Intensity:
Fold change:
Significance:
-
C’ GFP library in SD
cytosol25.39 -
N' NOP1pr-GFP in SD
cytosol57.5861 -
N' TEF2pr-mCherry in SD

cytosol49.1112 -
N' NATIVEpr-GFP in SD
cytosol28.0875 -
N' TEF2pr-VC and Cyto-VN in SD

cytosol43.6801 -
C’ GFP library in SD+DTT

cytosol22.850.89No -
C’ GFP library in SD+H2O2
cytosol25.320.99No -
C’ GFP library in Starvation Media

cytosol29.971.18No -
C’ GFP library on the background of Pup2-DaMP

cytosol -
C’ GFP library on the background of CCT mutant

cytosol25.97291.02267No
